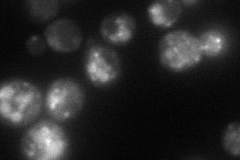
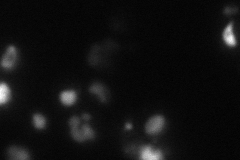
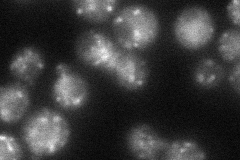
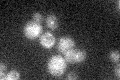

View description
Alpha-1,6-mannosyltransferase involved in cell wall mannan biosynthesis; subunit of a Golgi-localized complex that also contains Anp1p, Mnn9p, Mnn11p, and Mnn10p; identified as a suppressor of a cell lysis sensitive pkc1-371 allele
Localization:
Intensity:
Fold change:
Significance:
-
C’ GFP library in SD

punctate22.89 -
N' NOP1pr-GFP in SD
punctate,vacuole59.0821 -
N' TEF2pr-mCherry in SD
vacuole28.9718 -
N' NATIVEpr-GFP in SD
punctate46.6239 -
N' TEF2pr-VC and Cyto-VN in SD

#N/A0 -
C’ GFP library in SD+DTT

punctate18.090.79Yes -
C’ GFP library in SD+H2O2

punctate22.590.98No -
C’ GFP library in Starvation Media
punctate19.580.85No -
C’ GFP library on the background of Pup2-DaMP

punctate -
C’ GFP library on the background of CCT mutant

punctate19.59810.856054No
